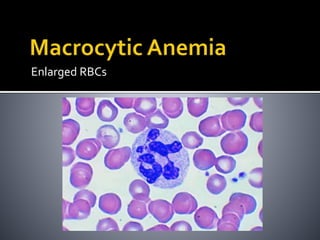
Enlarged RBCs

This document defines anemia and provides details about its causes, types, and treatment. It begins by defining anemia as a blood disorder where there is a deficiency in oxygen-carrying capacity due to reduced red blood cells or hemoglobin. The main causes of anemia include blood loss, red blood cell destruction, and insufficient red blood cell production. The document further classifies anemia into microcytic, macrocytic, and normocytic types based on red blood cell size, and lists specific conditions that fall under each type such as iron deficiency, B12 deficiency, and aplastic anemia. Common tests used to diagnose anemia and the information they provide are also outlined.